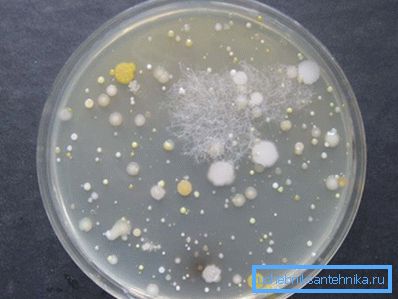

Was ist die analyse von wasser aus dem brunnen
Selbst von der Schulbank weiß jeder von uns, dass es sich bei einer Person um 75 Prozent Wasser handelt, sodass der Einfluss lebensspendender Feuchtigkeit auf unseren Körper schwer zu überschätzen ist.
Es sollte jedoch sofort gesagt werden, dass dieses Verfahren ziemlich mühsam ist. Daher werden wir weiter überlegen, wie und wo Wasser aus einem Brunnen analysiert werden soll.

Allgemeine Informationen
In vielerlei Hinsicht wird die Wasserqualität davon beeinflusst, woher sie kommt. Im oberen Grundwasserleiter, oberhalb der ersten wasserdichten Schicht, fließt Grundwasser, das eine große Menge an Verunreinigungen enthält. Dieses Wasser ist nicht zum Trinken geeignet, es wird nicht einmal für den technischen Gebrauch empfohlen..
Es ist bekannt, dass Gesteine in Schichten angeordnet sind, wodurch abwechselnde undurchlässige und durchlässige Schichten auftreten. Zwischen den wasserfesten Schichten befinden sich Grundwasserleiter, die als Zwischenschichtwasser bezeichnet werden. In den meisten Fällen ist dieses Wasser zum Trinken geeignet und hat eine sehr stabile chemische Zusammensetzung.

Brunnen graben sich in der Regel bis zum ersten interstratalen Horizont. Gleichzeitig kann die Tiefe ihres Vorkommens sehr unterschiedlich sein und es ist fast unmöglich, sie vorherzusagen. Die genauen Ergebnisse werden erst nach dem Bohren bekannt. Sie können jedoch zunächst die Nachbarn fragen, die Brunnen in ihren Abschnitten haben.
In einigen Fällen steht das Wasser in den Horizonten unter Druck und kann eine beträchtliche Höhe erreichen oder sogar einen Brunnen über der Bodenoberfläche verstopfen. Solche Horizonte werden als artesisch oder Druck bezeichnet.
Befindet sich der Aquifer in einer Tiefe von mehr als 10-15 Metern, ist es nicht ratsam, einen Brunnen zu graben. In diesem Fall ist ein Brunnen eine wesentlich effizientere Lösung.
Es ist zu beachten, dass die Wells in zwei Typen unterteilt sind:
- "Brunnen auf Sand" - ihre Tiefe liegt zwischen 15 und 35 Metern;
- "Kalksteinbrunnen" - die Tiefe kann bis zu 200 Meter oder mehr betragen.
Da sich in der Tiefe des letzteren oft Wasser befindet, werden solche Brunnen auch als artesisch bezeichnet.

Warum Analyse?
Selbst wenn sich Ihr Landhaus in einer ökologisch sauberen Gegend befindet, können Sie nicht sicher sein, dass das Wasser im Brunnen als Trinkwasser verwendet werden kann. Daher ist es notwendig, eine Wasserqualitätsanalyse vom Brunnen aus durchzuführen.
Beachten Sie! Grundsätzlich können Sie kein Wasser verwenden, dessen Zusammensetzung unbekannt ist. Es wird nicht einmal empfohlen, eine solche Flüssigkeit für Haushaltszwecke zu verwenden. Wenn es zu hart ist, bleibt die Waage auf Haushaltsgeräten, was dazu führen kann, dass sie zusammenbrechen.
Bei der Wasseranalyse werden ihre physikochemischen und mikrobiologischen Eigenschaften untersucht.
Im Rahmen chemischer Studien bestimmen Sie den Inhalt:
- Mangan
- Drüse;
- Ammonium;
- Sulfate;
- Bicarbonate sowie andere Substanzen.

Zusätzlich wird gemessen:
- Trübung
- PH;
- Steifheit;
- Alkalinität
Stellen Sie sicher, dass Sie Abweichungen von der Norm in Bezug auf Geruch und Farbe feststellen und deren Ursachen feststellen.
Das Vorhandensein einiger organischer Elemente wird auch festgestellt, wie zum Beispiel:
- Vinylchlorid;
- Dioxin.
Sowie einige anorganische Substanzen
- Quecksilber;
- Führen;
- Kupfer;
- Cadmium
Außerdem wird der Inhalt bestimmt:
- Herbizide;
- Pestizide;
- Insektizide mit ihren Derivaten.
Ein weiterer wichtiger Punkt der Analyse ist das Testen von Wasser auf Radionuklide:
- Alpha-Teilchen
- Radium usw.
Wasser aus flachen Brunnen sollte besonders sorgfältig untersucht werden, da es große Mengen an Schlacken enthalten kann. Im Hinblick auf die bakteriologische Analyse wird die Gesamtzahl der Bakterien sowie das Vorhandensein von Escherichia coli, Cholera, Typhus oder Dysenterie angezeigt.

So wählen Sie eine Wasserauswahl für die Analyse aus
Wann kann ich Wasser zur Forschung nehmen?
Zunächst sollte gesagt werden, dass es keinen Sinn macht, Wasser unmittelbar nach der Bohrung aus einem Brunnen zu analysieren. Damit das Ergebnis so objektiv wie möglich ist, muss der Brunnen für mehrere Wochen intensiv genutzt werden (nicht wie beabsichtigt). Erst danach werden alle verbleibenden Elemente nach der Brunnenvorrichtung ausgewaschen, einschließlich der Zementier- und Spüllösung sowie des Gesteins der oberen Bodenschichten, der Pumpenschmierung usw.
Zusätzlich ist es vor der Probenahme erforderlich, eine bakteriologische Behandlung der Vertiefung mit Natriumhypochloritlösung durchzuführen. Die Behandlung wird 12 Stunden lang durchgeführt, wonach das Wasser zwei Tage lang abgepumpt wird.
Tipp! Es ist ratsam, die Wasseranalyse zweimal - mehrere Wochen nach der Installation des Schachts und auch nach der Installation von Filtrationssystemen - durchzuführen.

Auswahl einer Wasserauswahl für die chemische Forschung
Das Wasser sollte in einem Glas- oder Kunststoffbehälter mit einem Volumen von 2-4 Litern gesammelt werden. Achten Sie darauf, dass der Behälter sauber ist und keine Fremdgerüche aufweist. Daher ist es nicht möglich, Bierflaschen als Behälter sowie Geschirr unter süßem Wasser oder technischen Flüssigkeiten zu verwenden. Darüber hinaus kann der Behälter nicht mit Reinigungsmitteln gewaschen werden.
Tipp! Es ist am besten, eine Flasche Mineralwasser ohne Kohlensäure für die Wasserprobenahme zu kaufen und es kurz vor der Probenahme zu drucken.
Andernfalls stellt sich heraus, dass die Analyse von schlechter Qualität ist, bzw. das Geld umsonst ausgegeben wird und die Kosten für die Analyse des Wassers aus dem Brunnen sehr hoch sind.
Auswahlanweisungen lauten wie folgt:
- Das Wasser muss für 20 bis 30 Minuten abgelassen werden, damit es aus einem Brunnen und nicht aus dem Hydrospeicher entnommen werden kann.
- Dann sollten der Behälter und der Deckel mit Wasser gespült werden, das von der Probe genommen wird, dann "unter dem Hals" wählen und fest verschließen.
- Um die Ergebnisse so objektiv wie möglich zu gestalten, sollte die Flasche entlang der Seite des Behälters mit einem dünnen Strahl gefüllt werden, um keine Reaktionen zu stimulieren.
- Nach der Entnahme muss das Wasser zwei bis drei Stunden lang an das Labor abgegeben werden. Je schneller die Analyse durchgeführt wird, desto zuverlässiger sind die Ergebnisse. Darüber hinaus sollten wir nicht vergessen, dass bei einer Wechselwirkung von Wasser mit Luft und Sonnenlicht chemische Reaktionen in ihm stattfinden, wodurch sich seine chemische Zusammensetzung ändert. Gefüllte Behälter müssen daher in einem engen Beutel transportiert werden.
Auswahl für die mikrobiologische Untersuchung
Die Hauptaufgabe der bakteriellen Wasseranalyse besteht darin, Informationen zur Anzahl und Zusammensetzung der Bakterien bereitzustellen. Daher ist es bei der Auswahl erforderlich, das Eindringen von Bakterien von Drittanbietern in die Flüssigkeit zu minimieren.
Führen Sie diesen Vorgang sorgfältig und schnell durch. Behälter müssen in diesem Fall steril sein. Es ist am besten, einen Behälter in demselben Labor zu kaufen, in dem die Analyse durchgeführt wird.
Auch wenn das Bohrloch nicht mehr neu ist und zuvor mit einer antibakteriellen Zusammensetzung behandelt wurde, muss dieses Verfahren vor der Probenahme wiederholt werden. Unmittelbar vor der Probenahme sollte das Wasser 15-20 Minuten abgesenkt werden. In diesem Fall muss der Hahn oder Mischer zuerst mit medizinischem Alkohol behandelt oder verbrannt werden.
Tipp! Es ist ratsam, Wasser mit medizinischen Handschuhen zu trinken, ohne den Hals zu berühren.

Wo soll die Analyse erfolgen?
Wasser kann zur Analyse dem SES oder einem privaten Labor zugeordnet werden. Es sollte gesagt werden, dass der Preis für Dienstleistungen in privaten Laboratorien in der Regel viel höher ist. Sie ermöglichen jedoch die Durchführung der Analyse nach allen Wünschen des Kunden. So können Sie beispielsweise den Inhalt jeder einzelnen Komponente ermitteln.
Fazit
Wie wir herausgefunden haben, ist es vor der Verwendung von Wasser erforderlich, vollständige Informationen über die Qualität zu erhalten, andernfalls kann es zu schweren Erkrankungen kommen. Wenn Sie eine wirklich objektive Analyse des Wassers aus dem Brunnen erhalten möchten, sollten Sie daran denken, dass Sie es mit Ihren eigenen Händen entsprechend den oben beschriebenen Regeln richtig auswählen müssen.
Weitere Informationen zu diesem Thema erhalten Sie in dem Video in diesem Artikel.